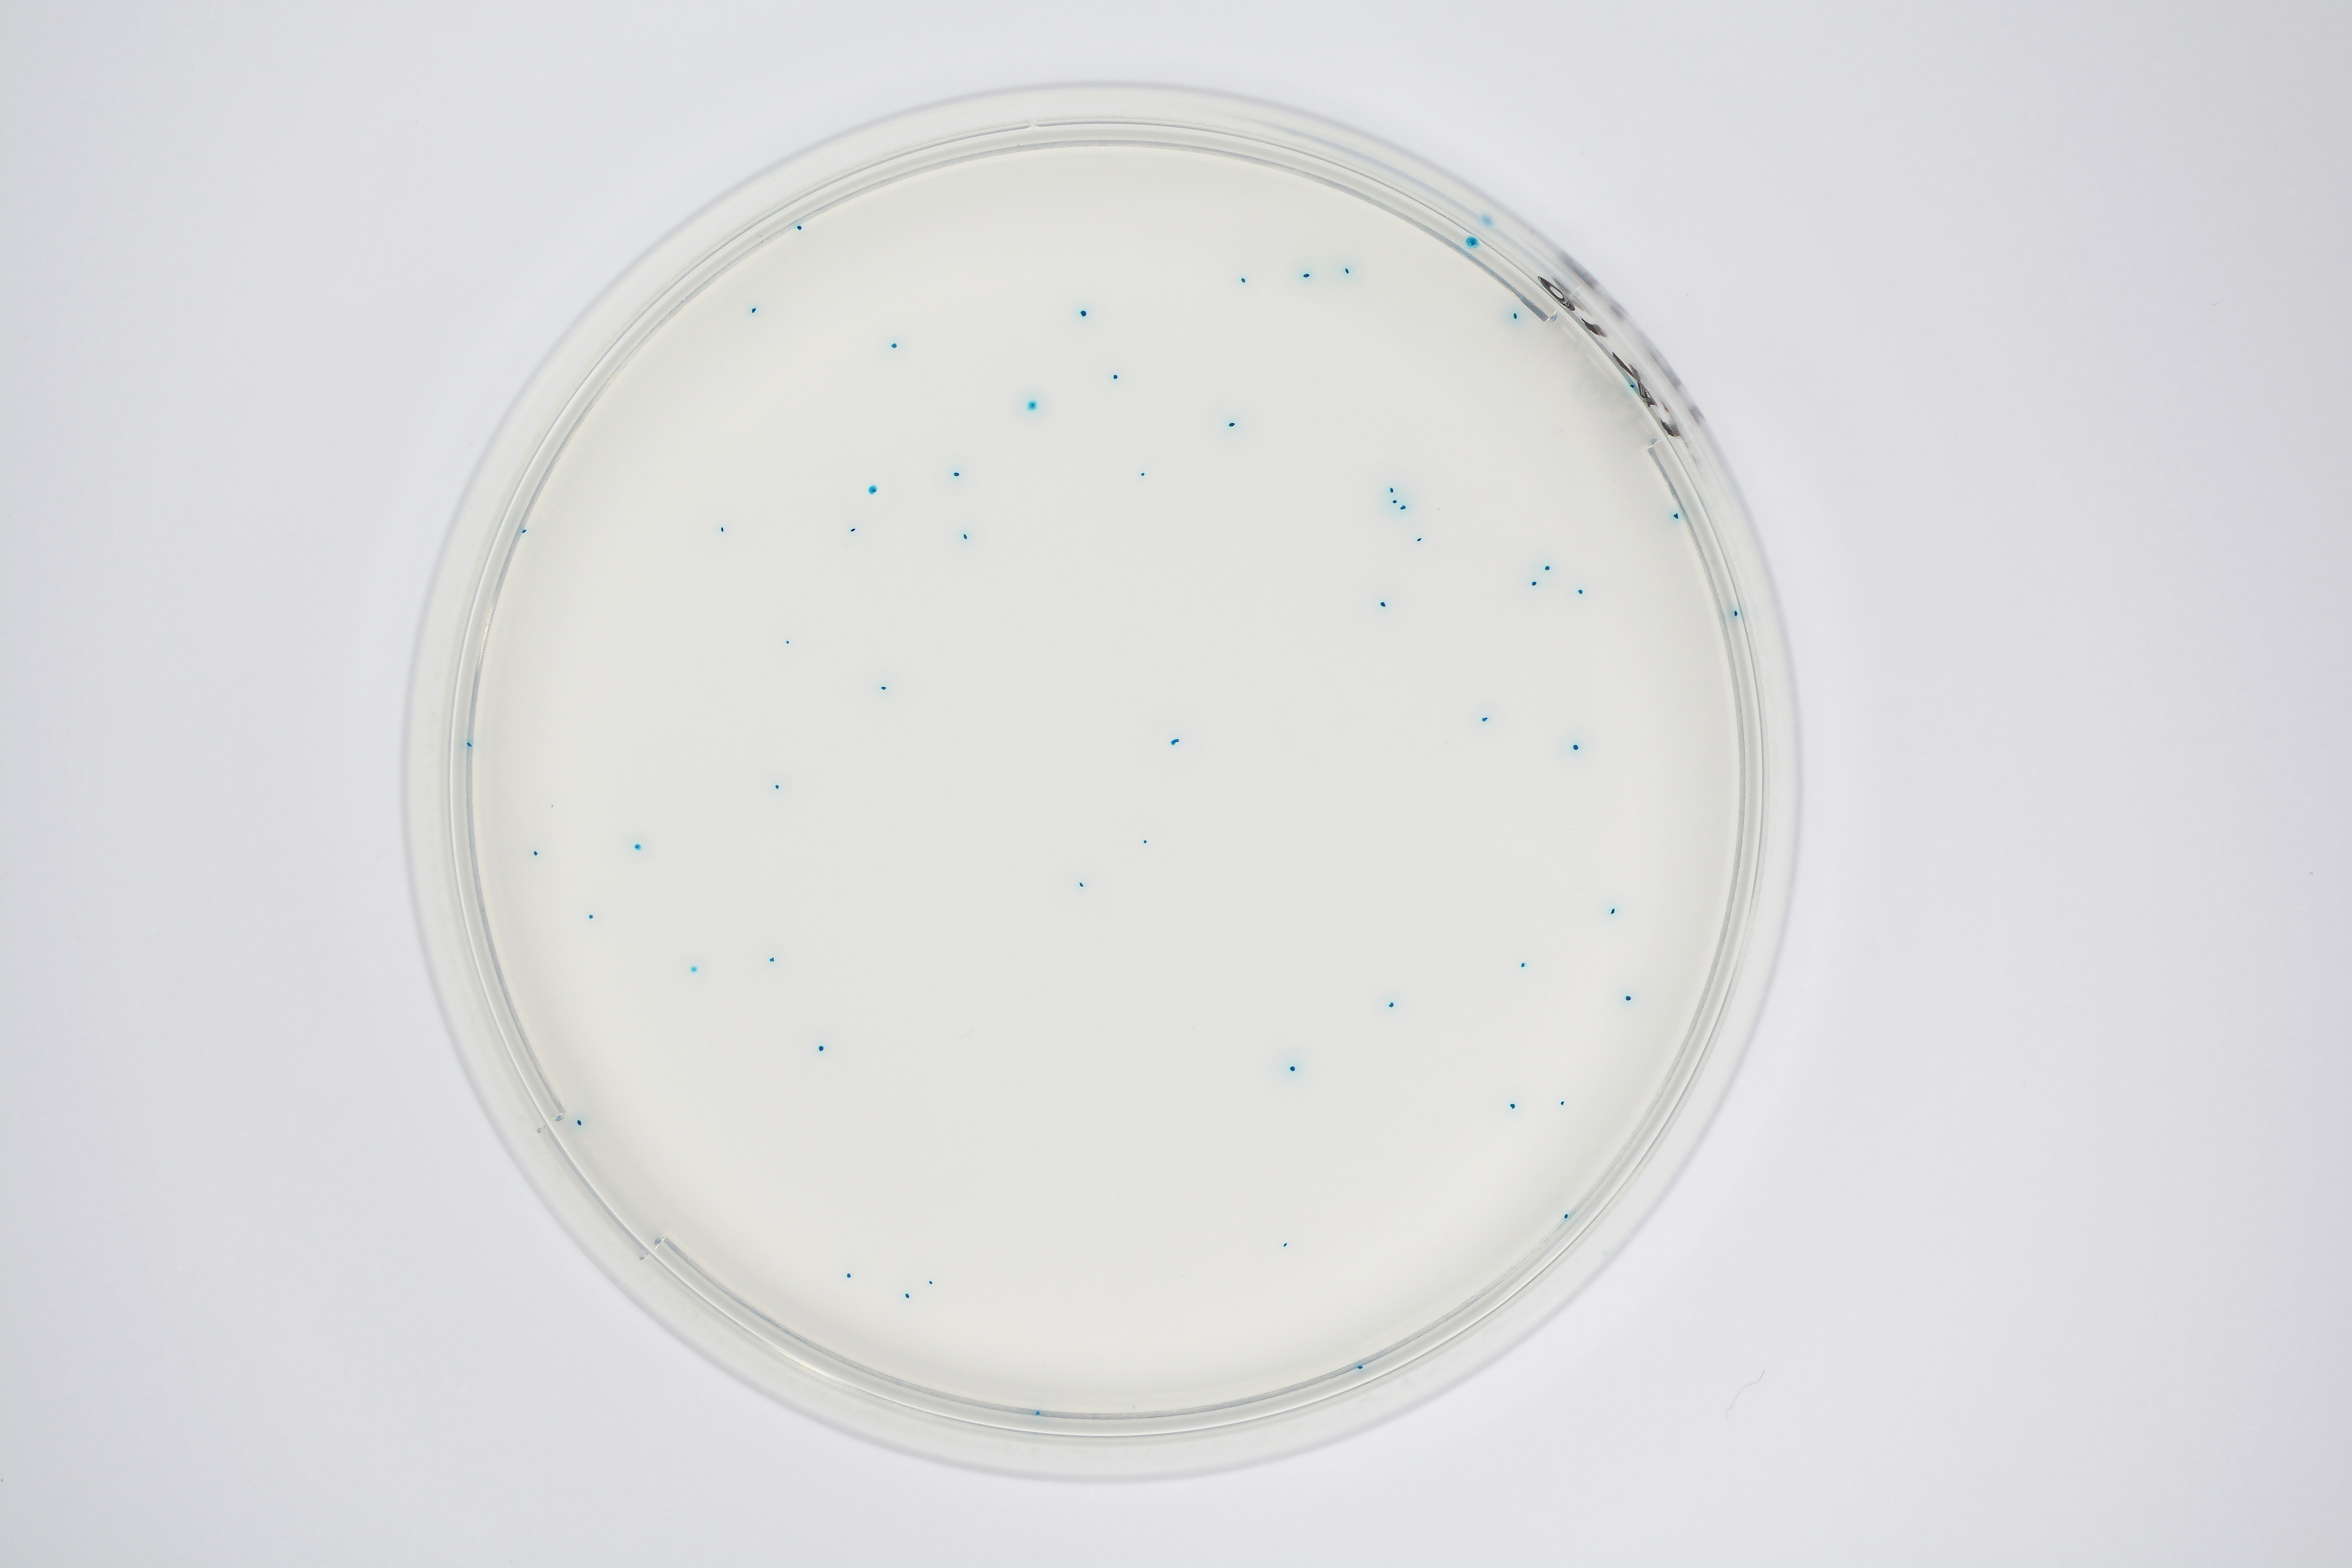

Description
Performances
Milieu chromogénique pour la détection et le dénombrement des E. coli ß-glucuronidase positifs dans des échantillons d’aliments et produits d’alimentation animale selon la norme NF EN ISO 16649.
La présence de E. coli indique une contamination fécale et la présence potentielle d’agents pathogènes dangereux tels que les bactéries Vibrio cholerae, Salmonella, Pseudomonas, etc ..., ou de virus et parasites intestinaux. Les infections résultant de l’ingestion d’aliments contaminés peuvent être dangereuses et mortelles.
La sensibilité de E. coli est de 96 % (Ogden et al. 1991).
De rares souches de E. coli ß-glucuronidase négatifs sont faux négatifs sur ce milieu (généralement E. coli 0157). Si la recherche se concentre sur des souches pathogènes rares telles que E.coli O157, merci de vous référer à notre produit CHROMagar O157.
Technical documents
To download the certificate of analysis, please indicate your lot number below: